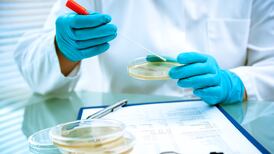
Listeriosis outbreak ‘unusual’ as ready meals must be cooked, and bacteria is sensitive to heat, professor says

Oisin Tymon, the Top Gear producer attacked by Jeremy Clarkson in a fracas which cost the BBC presenter his job has said he does not want to press charges against his former colleague.
Mr Tymon has told North Yorkshire Police he does not want to take any further action against Clarkson, who was this week told his Top Gear contract will not been renewed by the BBC after an angry and lengthy tirade in a hotel over food.
Mr Tymon's lawyer, Paul Daniels, today issued a statement in which he said: "Mr Tymon has informed the police that he doesn't want to press charges.
“The events of the last few weeks have been extremely unpleasant for everyone involved. The matter has taken a great toll on Oisin, his family and his friends.
“Quite simply, Mr Tymon just wishes to return now to the job at the BBC he loves, as soon as possible. Further, the BBC have, in his view, taken action with a view to addressing the issues at hand.
“Mr Tymon agrees with the BBC’s stated view that all parties should now be allowed to move on, so far as possible.”
North Yorkshire Police said the force is still investigating the incident, with a spokesman saying “inquiries are ongoing.”
PA